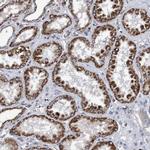
COBL Antibody in Immunohistochemistry (IHC)

Search
Invitrogen
COBL Polyclonal Antibody
{{$productOrderCtrl.translations['antibody.pdp.commerceCard.promotion.promotions']}}
{{$productOrderCtrl.translations['antibody.pdp.commerceCard.promotion.viewpromo']}}
{{$productOrderCtrl.translations['antibody.pdp.commerceCard.promotion.promocode']}}: {{promo.promoCode}} {{promo.promoTitle}} {{promo.promoDescription}}. {{$productOrderCtrl.translations['antibody.pdp.commerceCard.promotion.learnmore']}}
产品信息
PA5-53897
种属反应
宿主/亚型
分类
类型
抗原
偶联物
形式
浓度
规格
纯化类型
保存液
内含物
保存条件
运输条件
RRID
产品详细信息
Immunogen sequence: KSAHHEGRNP LGEGRNQPPT MGMGHVRVPA AHTTEVTFLK PQRRTSSQYV ASAIAKRIGA PKVHADVVRP HGYAEKGYAG KAPVLAAPPV TVKDDRTSSP HSETQGWKDG AQWPCVTPPN NHGEDLAVGA
Highest antigen sequence identity to the following orthologs: Mouse - 45%, Rat - 46%.
靶标信息
This gene encodes a cytosolic leucine-tRNA synthetase, a member of the class I aminoacyl-tRNA synthetase family. The encoded enzyme catalyzes the ATP-dependent ligation of L-leucine to tRNA(Leu). It is found in the cytoplasm as part of a multisynthetase complex and interacts with the arginine tRNA synthetase through its C-terminal domain. Alternatively spliced transcript variants of this gene have been found; however, their full-length nature is not known.
仅用于科研。不用于诊断过程。未经明确授权不得转售。
篇参考文献 (0)
生物信息学
蛋白别名: Protein cordon-bleu; unnamed protein product
基因别名: COBL; KIAA0633
UniProt ID: (Human) O75128
Entrez Gene ID: (Human) 23242